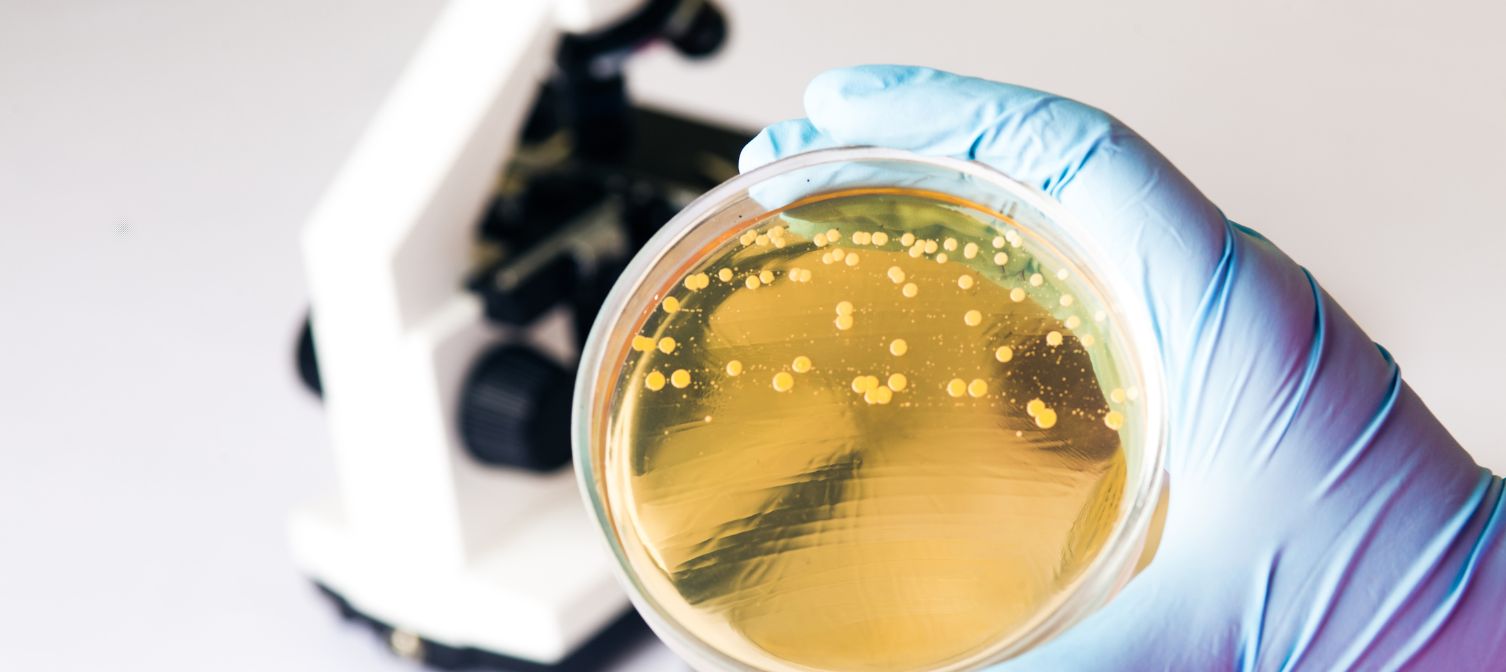
Wpływ pory dnia na mikrobiom

Mikrobiom decyduje o wielu sprawach związanych ze zdrowiem, nieraz zaskakujących – nastrojem, funkcjami mózgu, pracą serca. Naukowcy od pewnego czasu traktują florę jelitową bardzo poważnie i jej badanie jest obecnie jedną z podstawowych metod na określenie stanów chorobowych. Okazała się jednak, że wciąż nie wiemy wielu podstawowych rzeczy, które mogą zupełnie zmieniać wyniki badań. Na Uniwersytecie Kalifornijskim w San Diego odkryto bowiem, że skład mikrobiomu zależy w dużej mierze od pory dnia (wiadomo było wcześniej, że zależy od diety, trybu życia, genów itp). Mówiąc wprost, w różnych porach dnia dominują w nim różne gatunki bakterii, a różnice te dochodzą – w ciągu kilku godzin – do 80%! Tak więc badając próbki rano otrzyma się zupełnie inne wyniki, niż popołudniu czy wieczorem. A inne gatunki bakterii to inne wydzielane przez nie metabolity, które oddziałują na inne narządy, funkcje organizmu. Jednorazowe pobranie i zbadanie próbki może więc wprowadzić lekarzy w błędy, i to znaczne, może się skończyć postawieniem złej diagnozy i zaordynowaniem nieprawidłowego leczenia/profilaktyki. Zespół z San Diego wysunął już prośbę, by Narodowy Instytut Zdrowia (NIH) wymagał od uczonych i lekarzy określenia pory dnia, w której analizowano skład mikrobiomu. O tym ważnym odkryciu, jak to często bywa, zadecydował przypadek – doktoranci badający próbki rano i wieczorem osiągali inne wyniki, i oskarżali jedni drugich o złe diagnozowanie…